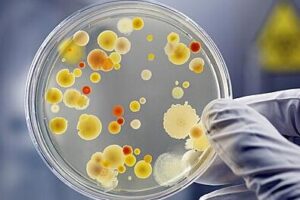
microbiologia 3

Bacterias halófilas: ejemplos y características únicas
Las bacterias halófilas son organismos unicelulares que pueden crecer en ambientes extremadamente salinos. En esta publicación, exploraremos algunos ejemplos de bacterias halófilas y sus características únicas. ¿Qué son las bacterias halófilas? Las bacterias halófilas son un tipo de microorganismo extremófilo que puede sobrevivir y crecer en ambientes con alta concentración de sal, como los cuerpos […]
Bacterias halófilas: ejemplos y características únicas Read More »